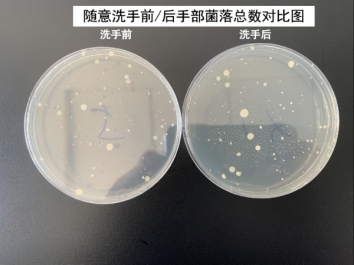

江苏省卫健委8月3日上午权威发布:8月2日0-24时,新增3例境外输入确诊病例。截至8月2日24时,累计报告境外输入确诊病例27例,尚在院隔离治疗4例。新冠疫情防控常态化阶段仍不容懈怠。
。
为防止各种疾病的发生,勤洗手成了人们的共识。8月3日,姑苏区疾控中心组织了“小小检验员”体验活动,10余位小学生通过观摩和实践,掌握七步洗手法的正确方法;通过操作和实验,了解了不同洗手方法效果的区别。

工作人员事先采集了5名工作人员不同洗手方式前后手部样品并进行了培养。实验检测结果表明,不论用何种方式洗手,洗手后细菌总数均有一定幅度的下降;但洗手效果差异较大。

姑苏区疾控中心提醒,最好选择流动清水配以洗手液或肥皂、七步洗手法来洗手,牢记“内外夹弓大立腕”口诀,即“洗手掌、洗背侧指缝、洗掌侧指缝、洗指背、洗拇指 、洗指尖、洗手腕手臂”七部。如果出门在外不方便使用流水洗手时,可以选择含乙醇的免洗手消毒液进行手清洁,具体方法为:取适量(2ml左右)消毒液置于手心,双手互搓使其均匀涂布每个部位,揉搓消毒1分钟,这样可以达到很好的消毒效果。

姑苏区疾病预防控制中心